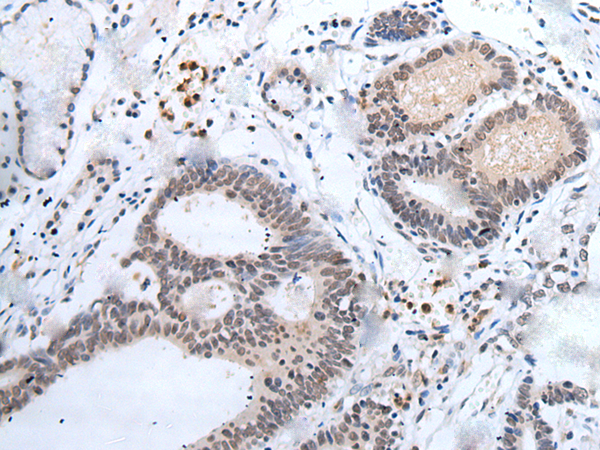

中文名稱: 兔抗MAGED1多克隆抗體
英文名稱: Anti-MAGED1 rabbit polyclonal antibody
別 名: NRAGE; DLXIN-1
相關類別: 一抗
儲 存: 冷凍(-20℃)
宿 主: Rabbit
抗 原: MAGED1
反應種屬: Human, Mouse, Rat
標 記 物: Unconjugate
克隆類型: rabbit polyclonal
技術規格
Background:
This gene is a member of the melanoma antigen gene (MAGE) family. Most of the genes of this family encode tumor specific antigens that are not expressed in normal adult tissues except testis. Although the protein encoded by this gene shares strong homology with members of the MAGE family, it is expressed in almost all normal adult tissues. This gene has been demonstrated to be involved in the p75 neurotrophin receptor mediated programmed cell death pathway. Three transcript variants encoding two different isoforms have been found for this gene.
Applications:
ELISA, IHC
Name of antibody:
MAGED1
Immunogen:
Synthetic peptide of human MAGED1
Full name:
MAGE family member D1
Synonyms:
NRAGE; DLXIN-1
SwissProt:
Q9Y5V3
ELISA Recommended dilution:
2000-5000
IHC positive control:
Human esophagus cancer and human thyroid cancer
IHC Recommend dilution:
25-100

購物車
購物車 幫助
幫助
 021-54845833/15800441009
021-54845833/15800441009
